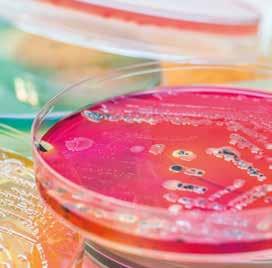

Cleaners, disinfectants and other tools for sanitizing the food processing environment Rapid hygiene solutions—a closer look Think It's Time to Verify Your Hygiene Program? Issue 8 A Romer Labs® Publication Photos: lisafx / IP Galanternik D.U.
Spot On is a publication of Romer Labs Division Holding GmbH, distributed free-of-charge.
ISSN: 2414-2042
Editors:
Joshua Davis, Cristian Ilea
Contributors: Meredith Sutzko, Stefan Widmann
Graphic: GraphX ERBER AG
Research: Kurt Brunner

Publisher:
Romer Labs Division Holding GmbH
Erber Campus 1
3131 Getzersdorf, Austria
Tel: +43 2782 803 0 www.romerlabs.com
©Copyright 2019, Romer Labs®
All rights reserved. No part of this publication may be reproduced in any material form for commercial purposes without the written permission of the copyright holder.
All photos herein are the property of Romer Labs or used with license.
Romer Labs is part of ERBER Group
Tools for Verification: Sanitizing the Processing Environment
Maintaining a clean and pathogen-free processing environment is a critical element in delivering safe products to consumers. Here, we get back to basics with an overview of cleaners, sanitizers, disinfectants and neutralizers.

 By Stefan Widmann, Product Manager Romer Labs®
By Stefan Widmann, Product Manager Romer Labs®
Rapid Environmental Hygiene Testing Technologies: A Closer Look
In this article, Stefan Widmann explains the most common types of environmental hygiene tests so that you can choose the right method for your operation.
By Stefan Widmann, Product Manager Romer Labs®
2 Spot On
8-11
4-7 Contents
Keeping the Processing Environment Clean: Challenges and Solutions
Food safety depends in part on the hygienic conditions in food manufacturing facilities. The presence of high levels of non-pathogenic bacteria can affect the shelf life and quality of foodstuffs for consumers. Equally important is the absence of pathogens (such as Salmonella and Listeria) in food that could potentially cause human illness. Food manufacturers must be diligent in keeping their processing environment clean and free of debris in order to limit cross-contamination of final product.
The chemicals you choose are instrumental for achieving sanitation goals. Cleaners are used to remove physical debris. Sanitizers help to reduce the presence of bacteria, while sterilants can be used to destroy microorganisms. A combination of these activities is typically performed in the food-processing environment. Sampling devices such as sponges and swabs are usually premoistened in neutralizing broths. These are intended to neutralize the activity of chemicals present on surfaces so that any microorganisms in the sample can grow in your selected testing method. With all these options to choose from, it is all the more important to find the right mix of chemicals for your program to be effective.
In this issue of Spot On, my colleague Stefan Widmann takes a look at the different testing technologies available to food manufacturers to verify compliance with their hygienic standards. He discusses, among other topics, the differences between ATP and routine microbiological counts and reviews the similarities and differences between DNA-based methods as compared to immunological methods. There is not one silver bullet for food processors; often, a combination of methods is necessary. Cost, accuracy, ease-of-use and time-to-result are critical attributes in selecting the right methods for your environmental hygiene testing.
The decisions that we make in sanitation and environmental monitoring programs are critical in our joint mission to supply safe food to consumers. We hope you enjoy this issue of Spot On!
Meredith Sutzko Product Manager, Romer Labs®

3 Editorial
A Romer Labs ® Publication
Tools for Verification: Sanitizing the Processing Environment
 By Stefan Widmann, Product Manager Romer Labs
By Stefan Widmann, Product Manager Romer Labs
4 Spot On Issue 8
There is no higher imperative for those in the food industry than ensuring the delivery of safe products to customers; maintaining a clean and pathogen-free processing environment is a critical element in fulfilling this mission. Contamination from environmental pathogens such as Listeria monocytogenes, or cross-contamination from pathogens with zoonotic origin such as Salmonella can cause major disruptions, especially if recalls are necessary. Any contamination can have a severely negative impact on a company’s reputation.
Food producers are confronted with what can be an intimidating series of choices in verifying an effective sanitation program. Here, we get back to basics with an overview of cleaners, sanitizers, disinfectants and neutralizers.
How to clean a processing environment
In sum, food processors can ensure that their processing environment is clean and sanitary by removing deposits and then by applying a sanitizer or disinfectant to reduce the number of residual microorganisms. Often referred to as “pre-cleaning”, the mechanical or physical cleaning is an important first step in any sanitization program. A mechanical cleaning increases disinfectant efficacy, and, in some cases, enhances log reductions. Several products for disinfecting and sanitizing surfaces are available to the food industry and have proven themselves useful in processing environments. In practice, a disinfectant, once selected, will remain the same for decades. Table 1 lists the most important considerations when choosing a sanitizer. Here, we review the significant differences between cleaners, disinfectants, food contact sanitizers, sterilants and neutralizers.
Easily applied
Non-toxic or of low toxicity to humans
No or discreet odor
Highly penetrative
Non-corrosive
Long shelf life
Compatible with hard water
Compatible with other cleaning chemicals
Fast-acting
Residual activity
Applicable to a broad spectrum (Gram+ bacteria, Gram- bacteria, yeast, molds and viruses)
Economic (cost-effective)
Cleaners
A cleaner is a detergent that assists in the physical or chemical removal of soil, dust, organic matter, and allergen residues. Usually, it is intended for use on specific areas (e.g. floors, walls, tables) and can be used on surfaces that come into contact with food. Cleaners may remove significant numbers of microorganisms, but they do not kill or eliminate them. Additional agents are required to disinfect or sanitize the surface.
Sanitizers
Sanitizers reduce but do not eliminate all microorganisms. Generally, food processors use them as part of good hygiene practice to reduce or eliminate pathogen contamination risk. A list of sanitizers is shown in Table 2.
There are two types of sanitizers:
1. Food contact sanitizers with disinfectant capabilities; these can be used on surfaces that come into contact with food and (also known as food contact surfaces, or FCS's).
2. Non-food contact sanitizers can only be used for surfaces that do not come into contact with food (Non-(also known as food contact surfaces, or FCS's).
Disinfectants
Broadly speaking, disinfectants include a combination of bactericides, fungicides, virucides, mycobactericides, tuberculocides, sporicides, and sterilants. There are various regulations governing how to test the efficiency of disinfectants. These tests generally verify the concentration of the disinfectant needed to kill certain microorganisms. The use of a disinfectant is appropriate for frequently touched surfaces and surfaces likely to harbor pathogens.
Sterilants
Sterilants not only reduce, but also destroy all types of microorganisms. They must demonstrate an absence of growth in test samples, or at least a 99.9999% (106
A Romer Labs ® Publication 5
Table 1. Characteristics of the perfect sanitizer solution
Source: Romer Labs
Mechanical or physical cleaning is an important first step in any sanitization program.
log) reduction. Sterilants include specialized chemicals such as glutaraldehyde, formaldehyde, and peroxyacetic acid. The term sterilization also refers to the non-chemical elimination of microorganisms using either dry heat (as in ovens) or moist heat (using steam under pressure or autoclaving).
Neutralizers: Which one to choose?
Sampling sites may be covered with residue from disinfectants used during the sanitation process. Food contact surfaces are often rinsed with fresh water after disinfecting and therefore may contain no or only negligible amounts of disinfectants. Sometimes, operators neglect to rinse drains, floors, walls and machine parts, with the result that these continue to harbor disinfectant residues. Microbial growth may be inhibited by these chemicals, but these remaining microorganisms are still alive and present a potential and ongoing pathogenic threat.
For microbiological sampling, it is vital to inhibit the effect of disinfectant residues. This is why sampling devices are pre-moistened with solutions that provide efficiency in neutralizing. Some of the most important
neutralizing solutions are Dey-Engley Neutralizing Broth (DE), Letheen Broth (LB) and so-called “neutralizing buffer” (NB), although there are also many other proprietary buffers on the market.
When it comes to choosing the right neutralizing solution, there are two main considerations: the toxicity of the solution itself and the efficiency of the neutralizing biocidal agents. The toxicity should be considered because the agents will also interact with the microorganisms, disturbing or even stopping their growth. As listed in Table 3, each biocide has its corresponding neutralizer. With each additional unnecessary neutralizing agent, the potential for harm to the target microorganisms increases.
While the type of neutralizer used in microbial sampling depends on which disinfectant is used, market availability is also a deciding factor. One of the most widely used neutralizing broths is Dey-Engeley broth. Developed by Dey and Engley in 1970, it has become one of the most effective neutralizing broths primarily owing to its broad range of neutralizing efficiency.
It is not insignificant that AOAC International refers
6 Spot On Issue 8
sanitizing Chemical Affected microorganisms Effective against spores Effective against biofilms Resistant or less sensitive microorganisms Chlorine (most common: Calcium and sodium hypochlorites) Bacteria, fungi, viruses YES NO Cryptosporidium, Giardia lamblia, Salmonella, Methicillin-resistant Staphylococcus Mixtures of Peroxide and Peroxyacetic acid Bacteria, fungi, viruses, mycobacterium tuberculosis YES YES Biofilms of Listeria (need longer exposure time), Salmonella, Escherichia coli Acid anionic sanitizers Bacteria, fungi, viruses, mycobacterium tuberculosis YES YES Biofilms of Listeria (need longer exposure time), Salmonella, Escherichia coli Carboxylic acid (fatty acid sanitizer) Bacteria, fungi, viruses, mycobacterium tuberculosis YES YES Biofilms of Listeria (need longer exposure time), Salmonella, Escherichia coli Hydrogen peroxide Bacteria, viruses, fungi YES NO Listeria (Biofilm) Quaternary ammonium compounds Vegetative bacteria NO YES Limited against gram negative bacteria Iodophors Bacteria, viruses, fungi NO NO No resistance Source: Romer Labs
Table 2. Chemicals used for
not kill or eliminate them.
Cleaners may remove significant numbers of microorganisms, but they
do
Table 3. Efficacy and toxicity of chemical neutralizers
Biocide Class
Glutaraldehyde, Mercurials
Phenolics, Alcohol, Aldehydes, Sorbate
Aldehydes Glycine Growing cells
Quaternary Ammonium Compounds (QACs), Parabens, Bis-biguanides Lecithin Bacteria
EDTA Mg+2 or Ca+2 ions
QACS, Iodine, Parabens
Mercurials
Mercurials, Halogens, Aldehydes
Source: Romer Labs
to it. A sugar source and a pH indicator was added to it, making it useful for sterility testing. A drop in the pH value indicates the growth of sugar-fermenting bacteria by turning the solution from purple to yellow. Yet this change in color is not necessarily helpful, as the subsequent detection or counting step after sampling renders it superfluous.
Polysorbate (Tween)*
Thioglycollate Staphylococci and spores
Sodium thiosulfate Staphylococci
Conclusion: customized solutions
Overall, deciding which chemicals are used to clean the processing environment and which neutralizers are used for microbial sampling are very specific to the requirements of the company. In-house evaluations are necessary to determine which chemicals and methods fit best.
There are two main considerations for the right neutralizing solution: the toxicity of the solution itself and the efficiency of the neutralizing biocidal agents.
Depends on wetting agents. Highly corrosive and extremely hazardous to skin. Can cause blistering, itching, scaling, or skin burns.
Depends on wetting agents. Highly corrosive and extremely hazardous to skin. Can cause blistering, itching, scaling, or skin burns.
Depends on wetting agents. Highly corrosive and extremely hazardous to skin. Can cause blistering, itching, scaling, or skin burns.
Can cause skin irritation.
on wetting agents. May bleach skin and cause irritation.
A Romer Labs ® Publication 7
Toxicity Odor Residual activity Hard water effects Organic matter effects Corrosive
and blisters. √ √ - √ √
Skin and respiratory irritant. Burning pain, inflammation
√ - - - √
√ - - - √
√ - - - √
- - √ √ √ Respiratory and skin irritant. √ √ √ √ -
- - - √ √
Depends
Neutralizer Neutralizer is toxic to:
Non-sporing
Bisulfate
bacteria
Dilution
Rapid Environmental Hygiene Testing Technologies: A Closer Look
 By Stefan Widmann, Product Manager, Romer Labs
By Stefan Widmann, Product Manager, Romer Labs
8 Spot On Issue 8
You have to meet your rigorous hygiene standards, and they in turn have to be verified. Stefan Widmann explains the most common types of environmental hygiene test in detail so that you can choose the right method for your operation.
Commonly used environmental testing technologies break down into two general approaches: testing for residues and testing for microorganisms. Here, we investigate the different technologies within each approach, how they work, and their applicability and advantages.
Residue Testing ATP methods
Adenosine triphosphate (ATP) is a nucleotide used in cells as a coenzyme for delivering energy. It can be thought of as the molecular “unit of currency" for transferring energy within all living cells. Energy is needed for all cellular activities including the synthesis of proteins and membranes, cell movement and cellular division. Energy is transferred when ATP breaks down into adenosine diphosphate and adenosine monophosphate. Hydrolyzing the covalent links of the phosphates liberates energy that is used for reactions.
Commercial ATP test systems harness the luciferin/ luciferase reaction, which is very common in nature, to generate visible light with the energy provided by ATP. The more light is emitted, the more ATP is present, which indicates more food residues or more microorganisms. Yet there is one important caveat: as these systems are widely used for cleaning efficiency validation, disinfectants are also commonly involved in the reaction. These disinfectants can disturb the cell walls of the microorganisms but preserve their ATP, meaning that there may not be a real correlation between living organisms present on the surface and the results of the ATP measurement.
ATP methods harbor a further potential disadvantage: they vary in their applicability depending on the food residue to be detected. For example, ATP testing would not lend itself to testing wheat flour as it is a highly processed matrix that leaves behind little ATP
in its residue. Meat product residue, however, contains high levels of ATP.
Total protein detection methods
As another residue testing approach, total protein detection methods test not for microorganisms themselves but rather for amino acids, peptides and proteins. These tests are very fast and deliver results within a minute. The detection is not sensitive enough to detect proteins from single-celled microorganisms. Therefore, a negative result with this type of test does not indicate an absence of the microorganism. Additionally, there is no way to detect specific pathogens using this method. Yet protein detection test kits have their use as they can give indications about cleaning efficiency in a fast and affordable way.
Microorganism Testing
Chromogenic cultural methods
These are the traditional methods for monitoring the hygiene of the processing environment. Cultural methods are addressed in ISO 18593, “Microbiology of the food chain – Horizontal methods for surface sampling.” Non-selective and selective media can be used to detect specific organisms.
Chromogenic Agar-based methods
Generally, there are two ways to conduct agar-based methods; either directly or indirectly via a dilution step. An advantage of both is that they provide quantitative results.
In direct methods, the agar of plates or dip-slides is pressed directly onto the surface being sampled. Contact plates have the shape of classic Petri dishes and typically have a surface area of 25 cm². Dip-slides are double-sided agar paddles protected by a plastic tube and have an agar surface area of 7-10 cm² on each side of
Commercial ATP test systems harness the luciferin/luciferase reaction; the more light is emitted, the more ATP is present.
A Romer Labs ® Publication 9
Photo: shutterstock_ Sirirat
In direct methods, the agar of plates or dip-slides is pressed directly onto the surface being sampled.

the paddle, which amounts to 14-20 cm². These systems require no additional equipment and the sampling procedure is very fast. However, the sampling area using this method is limited.
Swabs, tissues and sponges are tools for indirect sampling. After they are swabbed over the surface to be tested, they are then diluted in a buffer solution, which is then pipetted into traditional Petri dishes and streaked out. The tested surface area can be much larger and tight spaces and gaps can be tested with an indirect method. However, indirect methods have a downside: there are more handling steps and additional supplies are needed. For pathogen detection, the ISO standard recommends a surface area between 1000 cm² and 3000 cm²; an area this large can only be handled with sponges or swab cloths.

Chromogenic liquid media-based detection methods
This cultural method is only used to detect but not to count specific organisms or organism groups because it does not deliver quantitative results. In liquid media-based methods, swabs are used to take samples and are then placed into tubes filled with selective media. On average, incubation takes at least 48 hours for presumptive negative results. Positive samples are identified by a color change or florescence at a specific wavelength of the enriched sample. These tests are generally easy-to-use and affordable.
The disadvantage of liquid media-based systems is their low degree of sensitivity, a result of highly selective media, which intentionally suppress the growth of other bacteria. There is a certain risk here: bacteria in the processing environment are already stressed and can die if enrichment media are too selective. On the other hand, if the selectivity is too low, it can be difficult to detect specific microorganisms using selective liquid media alone. The interpretation of results can become difficult and subjective, as the color change or florescence is not always strong enough to indicate a definitive result. The main advantage of liquid media-based methods is that they are easy-to-use and affordable.
DNA-based methods
There are three different DNA-based methods: isothermal amplification of DNA, real-time and traditional PCR. Real-time PCR is an established method for the detection of DNA or RNA, while isothermal amplification is a more novel technology. There are clear advantages to using isothermal amplification over real-time PCR: for example, isothermal amplification requires no thermal cycler as the reaction takes place at a constant temperature. The most cost-effective but also most labor-intense DNA-based method is traditional PCR, because it is necessary to perform a hybridization step or to use a rather unspecific dye after amplification to detect amplified DNA or RNA.
In all methods, specific parts of the DNA or RNA are
10 Spot On Issue 8
There are several tools for sampling the food production environment, from dip-slides (left) to sponges (right).
recognized by specific primers and then multiplied by the enzyme polymerase. The sensitivity of these methods is remarkably high, and target regions in the DNA or RNA are well known. The biggest limitation of this system is that it is an enzyme-based system. Enzymes need specified buffer solutions to work properly. Ingredients in disinfectants can influence enzyme activity, which can lead to false negative results. The technology also requires multiple micro-pipetting steps, which can be a serious source of error.
The greatest advantage of DNA-based methods is that non-selective media can be used for the enrichment step thanks to the high sensitivity of the method. Non-selective media are affordable, available from various suppliers and require the lowest biosafety level (level 1). It is also possible to detect low amounts of pathogens on environmental surfaces without enrichment with DNA-based methods, but the sensitivity is low compared to that of enrichment-based methods. Lastly, false positive results from DNA fragments from pathogens that have already been killed could be a major problem.
Immunological methods
Immunoassays are systems that use antibodies to detect the presence of microorganisms in solutions. These antibodies can bind to antigens, such as lipopolysaccharides on the cell surface or flagella of particular microorganisms. After a single or multiple enrichment procedure that includes selective media, pathogens such as Listeria cells are detected with specific antibody-based testing systems.
ELISA (enzyme-linked immunosorbent assay) tests were the first to use immunological technology to detect specific microorganisms. ELISA allows for the quantification of the detected analyte, but the neces -

sity of including an enrichment step precludes any calculation of the initial concentration. Only trained staff can perform the multiple transfer and wash steps that ELISAs require. The development of lateral flow devices, also known as strip tests, solved this problem, rendering the immunological detection procedure much easier and quicker and eliminating the workload of ELISA tests. LFDs with selective antibodies used in combination with high-performing enrichment media enable fast and accurate results without the need for expensive equipment or costs related to training.
Conclusion
Choosing the right hygiene testing technology is not always an easy task. There are several practical considerations that will influence the decision: how many sampling sites must be tested and how important is testing throughput? How can testers optimize time-to-result, given that testing for some pathogenic bacteria is not conducted every day and is more a monitoring task than a quality control procedure? Are quantitative results needed, or is presence/absence testing sufficient? As it is still not possible to get bacterial counts immediately after cleaning, producers may rely on ATP or protein-based testing systems, which can serve as a vague indicator of whether it is safe to begin production, i.e. whether ATP or protein is present.
Also, national regulations can influence this decision. Enrichment-based DNA or immunological methods are superior to other methods in terms of sensitivity and selectivity and should be the systems of choice for pathogen detection. For detecting and counting indicator organisms or monitoring general hygiene, more affordable systems such as dip-slides or ATP systems may be used.
A Romer Labs ® Publication 11
Method ATP Protein Chromogenicagar Chromogenicliquid media ELISA LFD DNA/ RNA Sensitivity low low medium medium high high very high Selectivity low low medium medium high high high Labor low low medium medium high medium high Cost medium low low low medium medium high Time-to-result instant instant slow slow fast fast very fast Quantitative Results? yes yes yes yes no no no Source: Romer Labs
Table 1. Comparison of environmental hygiene testing technologies
Commonly used environmental testing technologies break down into two general approaches: testing for residues and testing for microorganisms.

YOUR ENVIROMENTAL MONITORING PROGRAM … unless you value dedicated service with • Tools customized to your needs • On-site training for you and your team • Technical support throughout the entire process Make environmental monitoring easy. Get a rapid, reliable and streamlined workflow, without having to invest in expensive equipment and intensive training. Learn why others made the change to Romer Labs at www.romerlabs.com/en/change/ CHANGE DON'T Your copy of Spot On Contact us for more information: www.romerlabs.com

By Stefan Widmann, Product Manager Romer Labs®
By Stefan Widmann, Product Manager Romer Labs®


 By Stefan Widmann, Product Manager Romer Labs
By Stefan Widmann, Product Manager Romer Labs
 By Stefan Widmann, Product Manager, Romer Labs
By Stefan Widmann, Product Manager, Romer Labs


